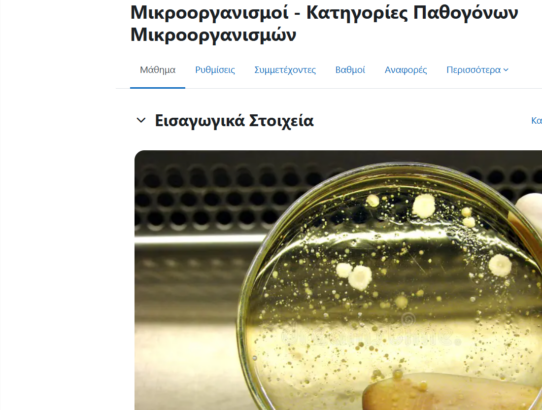
Moodle

MagicSchool
Το MagicSchool αποτελεί μία διαδικτυακή πλατφόρμα με τεχνητή νοημοσύνη η οποία είναι σχεδιασμένη ειδικά για εκπαιδευτικούς και σχολεία. Στόχος της είναι να βοηθάει τους δασκάλους να εξοικονομούν χρόνο και να βελτιώνει τη διδασκαλία και τη μάθηση. Μέσω της συγκεκριμένης πλατφόρμας μπορεί κανείς να δημιουργήσει υλικό διδασκαλίας (πλάνα μαθημάτων, φύλλα εργασίας, σκελετούς μαθημάτων). Ακόμα, το MagicSchool…
Read More